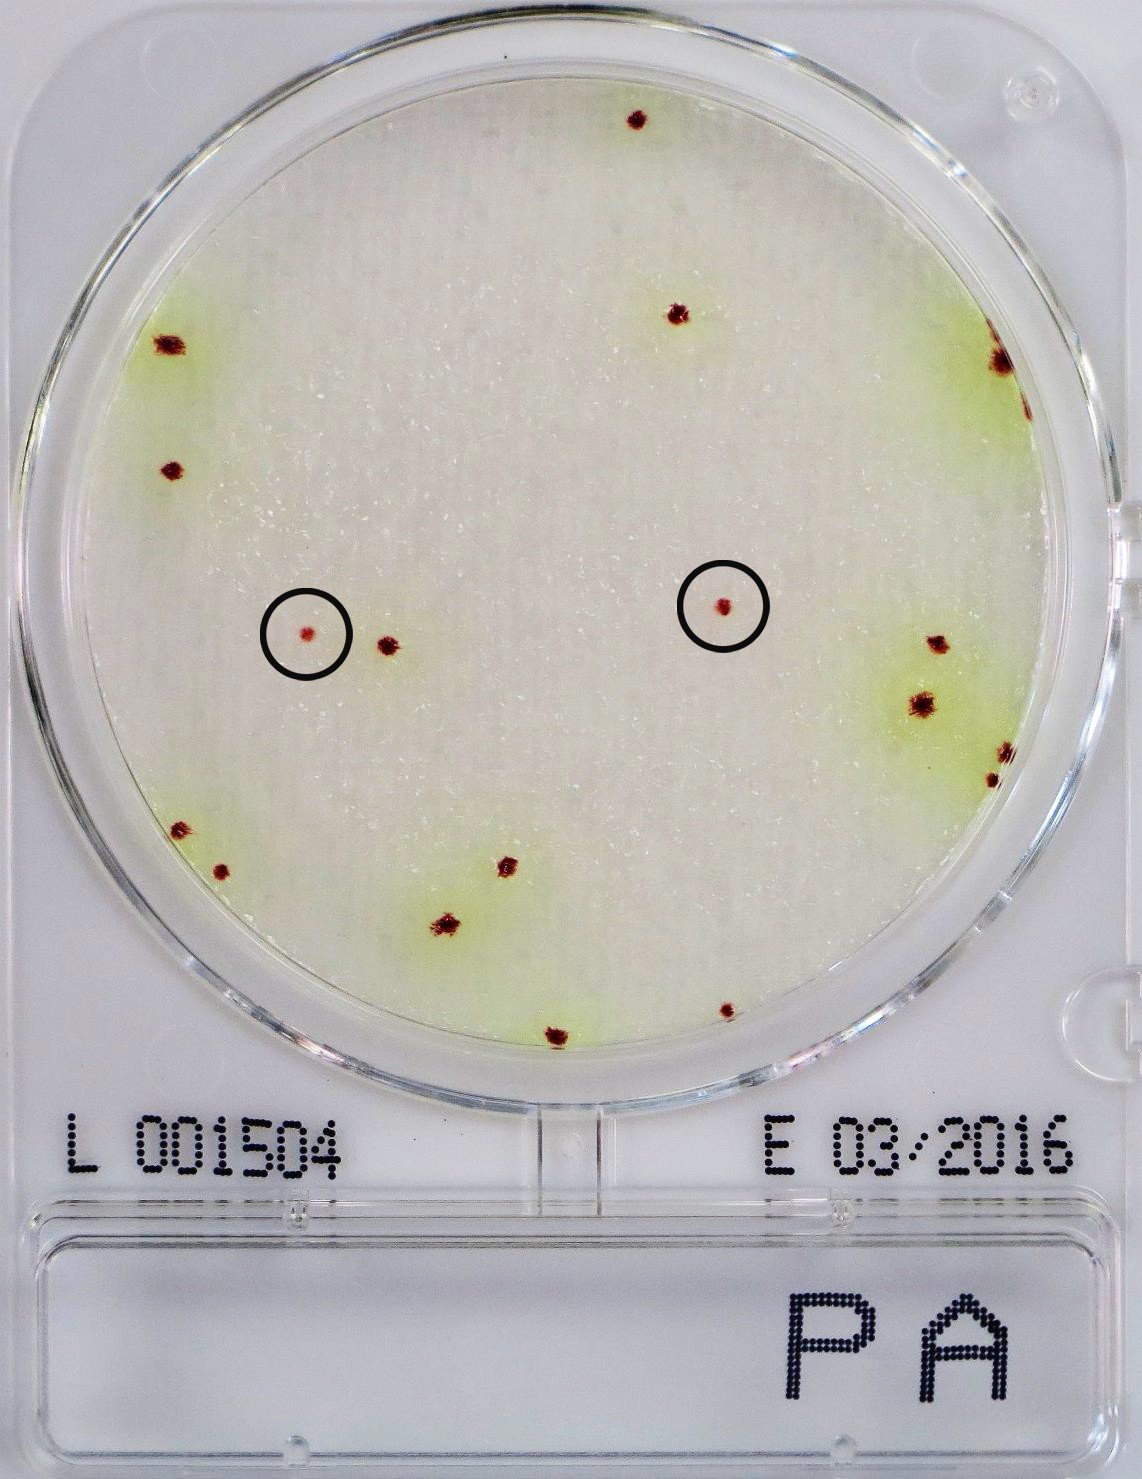

Compact Dry™ Prepared Media Plates - 54062-CS
Compact Dry™ is a simple and safe procedure to determine and quantify microorganisms in food and beverage, raw materials, cosmetics and pharmaceutical industries and internal environmental monitoring. The ready-to-use Compact Dry™ chromogenic plates are suitable for both in-process and final product controls.
- Ready-to-use
- Self-diffusing media - no need for a spreader
- Room temperature storage vs competitive products with storage at temperatures less than or equal to 8ºC
- Rigid transparent plates with removable lid - no leakage
- Innovative stacking design
- Easy to label
- Ability to subculture without damage to colonies
- Widest available parameters and broadest application
- Convenient, fast and accurate results
Pseudomonas is a psychotropic bacterium that can survive and thrive at low temperatures; because of this, it is a known causative agent of spoilage in refrigerated products, such as red meat, poultry, fish and milk and milk products. known to cause spoilage of refrigerated products such as red meat, poultry, fish and milk and dairy products. milk and dairy products. They are ubiquitous in nature and can thrive in soil, freshwater and marine environments. Their Their ability to survive is based on the wide range of environmental requirements, such as water activity, salt concentration and temperature. salt concentration and temperature. Therefore, in addition to foodstuffs, they are also known to contaminate the clinical environment and cosmetic and pharmaceutical products. The increase in the quantity of such bacteria tends to decrease the quality and safety of foodstuffs. the quality and safety of food by increasing the risk of disease.
You've got questions, we've got answers.
Reach out and let's see what we can do together.